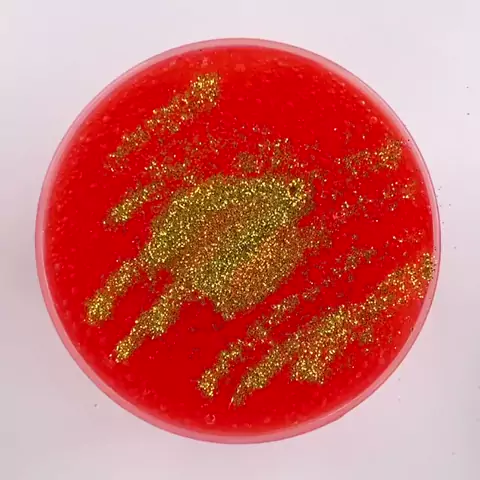

Follow
5
0
0
νΌλμλ³Όμ¬λΌμ
π골λ 체리μ€λ²³πνκ΅νμ€λ²³ (μμ΄μ€μ²΄λ¦¬ν₯)κΈ°μ‘΄ λ§€μ€μ€λ²³λ³΄λ¨ μ«μ«νκ³ νμΈμ νμ €λ¦¬μ€λ² νΈλ³΄λ¨ μ¬λ₯΄λ₯΄νμ«ν±μ€λ²³μ
λλ€ γ
.γ
μλΆμμ΄ μ μ΄ μ΄λ³΄μλΆλ€λ μ½κ²λ§μ§μ€ μ μμ κ² κ°μμμ μ°ν λλμμ κΈ°ν¬κ° λ§μ΄ μ°¨λ©΄ μ¬λ₯΄λ₯΄ν μ§κ°λ μ¦κΈ°μ€ μ μμ΅λλ€ βπ»μ²μ λ§‘μ λ 체리ν₯μ΄μ§λ§ λμ μμν ν₯μ΄ κ°μ΄ λκΈ°μ‘΄μ 체리ν₯λ³΄λ€ λμ± μ’κ² λκΌμ΄μ ππ»#νΌλμλ³Όμ¬λΌμ
More
Comment
Cancel
Send